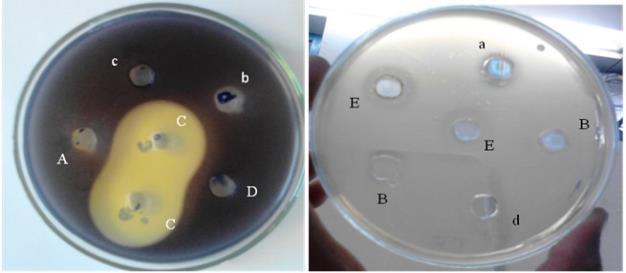
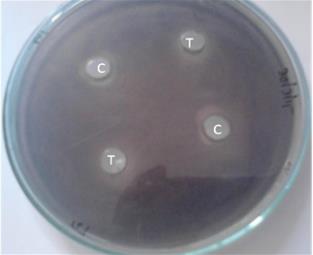

Int J Pharm Pharm Sci, Vol 8, Issue 1, 76-82Original Article
ANTI QUORUM SENSING POTENTIAL OF MORINGA OLEIFERA SEED EXTRACT
SARADA JONNALAGADDA*1, UMA KRANTHI DESHABATHINI2
*1Assistant Professor, 2Project Fellow, Department of Microbiology, Bhavan’s Vivekananda College, Sainikpuri, Secunderabad, Telangana State, India 500094
Email: saradavenkatj@rediffmail.com
Received: 27 Jul 2015 Revised and Accepted: 18 Nov 2015
ABSTRACT
Objective: Most infectious diseases caused by bacteria are known to be regulated by Quorum-sensing mechanisms which in turn regulate the pathogenicity. Evaluation of phytochemicals present in Moringa plant extract for potential (QSI) Quorum sensing inhibitory activity was undertaken in this study.
Methods: QSI activity was evaluated using bioindicator organism Chromobacterium violaceum 12472. Biofilm dispersal activity of the QSI compound was evaluated by microtitre plate method. Individual bioactive components were extracted and analyzed by (TLC) Thin Layer Chromatography. Mechanism of the action of (MSE) Moringa seed extract was evaluated by LCMS analysis.
Results: Preliminary evaluation of different parts of Moringa oleifera extracts revealed that aqueous seed extract had shown a large turbid zone of violacein pigment inhibition when tested for Quorum sensing inhibitory activity with bioindicator organism Chromobacterium violaceum 12472 then the other plant parts. As the virulence factors like biofilm formation is regulated by Quorum sensing, biofilm dispersal activity was evaluated with selected bacterial pathogens. Biofilm dispersal activity was more in Pseudomonas (35%) and Klebsiella (25%) than the other pathogenic strains tested. Phytochemical components like saponins, cardiac glycosides, triterpenes, phytosterols and volatile oils were identified in aqueous Moringa Seed extract. After extraction and Thin Layer, Chromatography analysis only cardiac glycosides and saponins were found to have Quorum sensing inhibitory activity against Chromobacterium violaceum 12472.
Conclusion: In the present study the Quorum sensing inhibitory activity of crude Moringa Seed extract was observed to be more than the individual compounds like cardiac glycosides and saponins alone. Attempts were made to understand the mechanism involved in Quorum sensing inhibitory activity. Present results give an opportunity to explore the possible usage of Moringa Seed extract in treating biofilm formation by bacterial pathogen.
Keywords: Quorum sensing inhibition, Chromobacterium violaceum 12472, Moringa oleifera, Biofilm, Phytochemicals.
© 2016 The Authors. Published by Innovare Academic Sciences Pvt Ltd. This is an open access article under the CC BY license (http://creativecommons.org/licenses/by/4.0/)
INTRODUCTION
Most infectious diseases caused by bacteria are known to be regulated by (QS) Quorum-sensing mechanisms which in turn regulate the pathogenicity. Efforts to block or interrupt QS signaling cascades in bacteria have enabled the identification of bioactive molecules with (QSI) quorum sensing inhibition activity or quorum quenchers. Recently phytochemicals are reported with potential QSI activity. Researchers are increasingly investigating herbal products as nontoxic inhibitors of QS, thus controlling infections without developing resistant bacterial strains. At present 10% of all terrestrial flowering plants have been used by different communities for treating diseases and only 1% have gained recognition and validation [1]. Thus, phytochemicals may represent the richest available reservoir of novel therapeutics like traditional systems of medicine, modern medicines, nutraceuticals, food supplements, folk medicines, pharmaceutical intermediates and chemical entities for synthetic drugs.
Several research papers were published indicating the potential of the plant extracts in treating microbial infections through quorum sensing inhibition. Both extracts and individual molecules from various types of fruits, herbs and spices have shown an ability to inhibit QS [2-6]. Attempts were made to screen plant extracts for potential QSI activity. Preliminary evaluation of medicinal plant extracts of Indian origin had revealed that Moringa oleifera plant extract had QSI activity.
Moringa oleifera Lam (Moringaceae) is an important food commodity which is known as the ‘natural nutrition of the tropics’. The leaves, fruit, flowers and immature pods of this tree are used as a highly nutritive vegetable in many countries, particularly in India, Pakistan, Philippines, Hawaii and many parts of Africa. M. Oleifera is referred as ‘drumstick tree’ or ‘horseradish tree’. In the Nile valley, the name of the tree is ‘Shagara al Rauwaq’, which means ‘tree for purifying’. Different parts of this plant contain a profile of important minerals and are a good source of protein, vitamins, β-carotene, amino acids and various phenolics. It has an impressive range of medicinal uses with high nutritional value [7]. Hence, present work was carried out to evaluate the QSI activity of different parts of Moringa plant and identify the bioactive compound exhibiting QSI activity.
MATERIALS AND METHODS
Microorganisms used in the study
Bacterial strains were cultured in Luria-Bertani (LB) broth. Chromobacterium violaceum 12472was grown at 28 °C (Wild, used in quorum signal inhibition screens, indirect acyl HSL detection, obtained from Dr. Hammeda bee, Asst. Professor, Department of Microbiology, Osmania University). Chromobacterium violaceum 12472is a standard bioindicator organism used globally for QSI activity testing. Bacterial cultures like Pseudomonas sp, Serratia sp YAJS, Bacillus sp and Klebsiella pneumoniae, Proteus vulgaris were used to test biofilm dispersal activity andwere routinely cultured at 37 °C.
Preparation of crude extracts
Different parts of Moringa oleifera plant was obtained from our college campus during the winter season and those were authenticated by Botany department. For initial screening of QSI activity, fresh extracts of flower, pod, bark, leaves and seed were used. Crude extracts were prepared by crushing the plant parts to get a final concentration of 1g/10 ml milliQ water. As Moringa seed extract has more potential activity, further work was carried out with the concentrated extract of seed. 20g of fresh seeds were ground to fine paste, mixed in 100 ml of milliQ water and boiled. The extract was then concentrated to 10 ml using Rotavap.
Virulence factors tested
Virulence factors like pyocyanin production, protease activity and swarming nature of Pseudomonas aeruginosa were tested before and after treatment with different Moringa plant parts by using protocols mentioned in our previous publication [8].
Bioassay
QSI activity of crude extracts of Moringa was tested by violacein inhibition assay using Chromobacterium violaceum 12472as bioindicator organism. The nutrient agar plates were pre-seeded with the overnight grown culture of Chromobacterium violaceum 12472. Wells were made in the agar plate with a sterile cork borer of 6 mm in diameter. The wells were loaded with 50 μl of the samples and incubated overnight at 30 °C. The QSI activity was calculated by measuring the diameter of colorless haloes created due to inhibition of violacein pigment but not the growth [9].
Screening for Biofilm dispersal activity
Biofilm dispersal activity was tested using clear 96 well flat bottom polystyrene microtitre plates. Bacterial strains were grown for 48-96 h and diluted 1:100 in fresh LB. 200 μl of cultures were added to every well of a microtiter plate and incubated for biofilm formation. After 20-28 h of growth and biofilm development, 50 μl of MSE was added and incubated for 1 h at 37 °C for assay. All non-attached cells were removed by discarding the culture medium and rinsing the plate in a container by immersing and agitating gently four times in tap water. Attached biofilm material was stained by addition of 250 μl of 0.5% (CV) crystal violet solution to each well of the plate for 10 min. Unbound stain was removed by aspiration and the plate was rinsed again in tap water until no more stain was observed to dissolve in the water. The plates were air dried and photographed. Subsequently, 250 μl of 96% ethanol containing 2% acetic acid (v/v) was added to each well. Adsorption at 595 nm was measured using an ELISA plate reader with appropriate controls [10].
Phytochemical analysis
Aqueous crude extract of (MSE) Moringa oleifera seed was subjected to qualitative analysis for identification of phytochemicals like Saponins, Phenols, Tannins, Cardiac glycosides, Flavonoids, Alkaloids, etc by following published protocols from these references [11-17].
Identification of saponins by haemolytic activity
Sheep erythrocytes were separated by centrifuging 1 ml of sheep blood at 8000 rpm and then diluted with (PBS) phosphate buffer saline to get a 10% and 50% suspension. To 1 ml of serially diluted Moringa seed extract, 50 µl of diluted and undiluted sheep blood was added and incubated for 60 min at room temperature. Samples were centrifuged at 3000 rpm for 5 min. The absorbance of the supernatant was measured at 540 nm [18]. Haemolytic activity was identified by complete or partial haemolysis.
Extraction of phytochemicals and TLC analysis
Saponins from Moringa seed were extracted using thee different protocols with different solvents like hydrochloric acid [19], 32% hydrochloric acid [20] and benzene [21]. Out of the three protocols, extraction of saponins using benzene has given a better yield. The sample was further analyzed by TLC (5x4 cm) following the conditions mobile phase-Pyridine: Butanol: water (3:2:1). Saponin fraction with QSI activity was identified by overlaying TLC plate with bioindicator organism Chromobacterium violaceum 12472.
Extraction of triterpenes was carried out by the protocol of J. B. Harborne, 2011 [22] wherein the Moringa seeds were first defatted with ether and later extracted with hot methanol. The concentrated methanol extracts were then examined directly by TLC. These fractions were further tested for triterpenes, phytosterols, and cardiac glycosides by performing TLC’s at specific conditions as mentioned in J. B. Harborne, 2011 [22]. The phytochemical fraction with QSI activity had been screened by overlaying with bioindicator organism Chromobacterium violaceum 12472.
LCMS analysis
LCMSanalysis was carried out to study whether the signal molecule AHL is intact or degraded during treatment with the crude extract of Moringa seed. LCMS was performed with C18 column for separation in an Acetonitrile (ACN) water gradient (The column is initially eluted with 10 % Acetonitrile (ACN) at 1 ml/min for 10 min followed by a linear gradient to reach 100% ACN in 65 min and an additional 15 min at 100% ACN). In the generated MS data, m/z peak corresponding to 101/102 (lactone fragment) was checked [23].
RESULTS AND DISCUSSION
Different parts of Moringa oleifera plant were medicinally important as they reported to act as cardiac and circulatory stimulants, possess antitumor, antipyretic, antiepileptic, antiinflammatory, antiulcer, antispasmodic, diuretic, antihypertensive, cholesterol lowering, antioxidant, antidiabetic, hepatoprotective, antibacterial, antifungal activities. They are employed for the treatment of different ailments in the indigenous system of medicine, particularly in South Asia. Hence, leaves, roots, seed, bark, fruit and flowers of Moringa plant were screened for the effect of virulence factors on Pseudomonas aeruginosa (table 1) and QSI activity by violacein inhibition assay using bioassay indicator organism Chromobacterium violaceum 12472. Out of all the extracts, only MSE could reduce the virulence factors like pyocyanin production (96%), protease activity (74%), and swarming nature (60%) which are crucial for Pseudomonas infection. QSI activity of MSE was more which can be seen as a large turbid zone of violacein pigment inhibition (fig. 1) than the other extracts tested. These results were indicating that phytochemical components present in seed have potential QSI activity.
Table 1: Effect of Moringa oleifera extracts on virulence factors of Pseudomonas and their QSI activity
Parts of Moringa oleifera |
Growth A600 |
Pyocyanin A520 |
Protease A660 |
Swarming |
QSI activity |
Leaf |
Nil |
Nil |
58% |
56.7% |
Nil |
Flower |
Nil |
Nil |
Nil |
42.3% |
Nil |
Seed |
Nil |
96% |
74% |
60% |
50% |
Bark |
Nil |
Nil |
Nil |
Nil |
25% |
Pod |
Nil |
Nil |
Nil |
Nil |
Nil |
As swarming nature of Pseudomonas had reduced by 60%, biofilm dispersal activity of MSE was tested. Biofilms pose threat to antibiotic treatment because of their drug resistance. Currently, biofilms are estimated to be responsible for over 65% of nosocomial infections and 80% of all microbial infections. Biofilm is an aggregate of microorganisms in which cells are stuck to each other onto a surface and produce matrix of extracellular polymeric substance. QS is used to coordinate gene expression and regulate numerous processes that are involved in virulence such as motility and biofilm formation [24]. Several opportunistic pathogens rely on biofilm formation and quorum sensing for controlled expression of virulence factors in the process of establishing persistent infections in humans and animals.
Hence, QS and biofilm offer targets not only to control the development of drug resistance but also to aim the pathogen and reduce the severity of infection. Thus, (QSIs) QS inhibitors would become a double-edged swords blocking QS-mediated biofilm formation (and hence the development of drug resistance) and also the production of some virulence factors. Several QSI from nature has been identified to inhibit biofilm formation [24].

Fig. 1: Quorum sensing inhibition activity of different parts of Moringa plant
In this context, an attempt was made to investigate the biofilm dispersal activity of the MSE. Dispersal of biofilms of both gram positive and gram negative bacteria like Pseudomonas, Klebsiella, Proteus, Serratia and Bacilli were carried in a standard biofilm dispersal assay using a 96 well microtiter plate. All bacterial cultures were grown in microtiter plate for 24 h for biofilm formation. Later dispersal assay was carried out by adding crude extract, followed by incubation, staining with crystal violet (0.5%) and destaining. Attached biofilm was analyzed by measuring absorbance at 595 nm with ELISA reader.
From the results depicted in fig. 2 and fig. 3, maximum biofilm dispersal activity was more in Pseudomonas (35%) and Klebsiella (25%). However, it had very less effect on gram positive like Bacillus sp. Present results suggest that MSE had QSI compounds which were more effective in Pseudomonas and Klebsiella alone. The significance of this result implies that MSE can effectively inhibit Pseudomonas biofilms which generally drug resistant and form biofilms on medical devices like urinary catheters, cannula, stents, and valves.
Further work was carried out to identify the phytochemical component responsible for QSI activity. As diverse class of phytochemicals were known to present in crude plant extracts, initially qualitative analysis were performed as per the standard protocols to detect their presence. Results obtained were specified in table 2. This preliminary analysis had revealed the presence of phytochemicals like saponins, cardiac glycosides, triterpenes, phytosterols and volatile oils in MSE.

Fig. 2: Biofilm dispersal activity of MSE
As MSE contained different classes of phytochemicals, the next step was to segregate these phytochemicals and identify the bioactive component. Individual phytochemicals were extracted with different solvents and then separated by employing specific TLC conditions for each class of phytochemicals. Initially, MSE was subjected to TLC analysis assuming that individual phytochemical components would segregate. TLC of crude MSE was performed by using mobile phase-Butanol: ethanol: Ammonia (7:2:1). Spots were identified by exposing the TLC plates to iodine fumes (fig. 4).

Fig. 3: Microtitre plate showing Biofilm dispersal activity 1. Pseudomonas, 2. Klebsiella, 3. Proteus, 4. Serratia, 5. Bacilli
Two spots have been resolved with a Rf values: 0.7, 0.8 cm. To confirm the QSI activity of resolved spot, plates were overlayed with biosensor organism Chromobacterium violaceum. QSI activity was observed as hazy zone of depigmentation on the spots (fig. 5).

Fig. 4: TLC of Moringa seed aqueous extract

Fig. 5: QSI activity of moringa seed. Mobile phase: butanol: ethanol: ammonia (7:2:1) aqueous extract
Based on the preliminary qualitative analysis of MSE, saponins were found to be abundant. The formation of persistent foams during plant extraction or during the concentration of plant extracts was reliable evidence that saponins were present. However, saponins can also be tested in crude extracts by their ability to hemolyze blood cells. Hence haemolytic activity of MSE was checked for confirmation of saponins. Dilutions of MSE were mixed with 10% and 50% of sheep erythrocytes with phosphate buffer and were incubated at room temperature for 1h. Haemolytic activity was identified by complete or partial hemolysis. Hemolysis was observed to be concentration dependent as depicted in fig. 6. Between the two dilutions tested for haemolytic activity, 50% dilution of sheep erythrocytes showed more haemolytic activity than with 10%.
Table 2: Phytochemical analysis of aqueous Moringa seed
S. No. |
Test and methods |
Reaction |
1. |
Phenols |
|
Ferric chloride test |
- |
|
Libermann’s test |
- |
|
2. |
Tannins |
|
Ferric chloride test |
- |
|
Gelatin test |
- |
|
3. |
Flavonoids |
|
Dilute NaOH |
- |
|
Ammonia |
- |
|
Lead acetate |
- |
|
Shinoda test |
- |
|
4. |
Quinones |
|
Conc. H2SO4 |
- |
|
5. |
Saponins |
|
Froth test |
+ |
|
Foam test |
+ |
|
Honeycomb froth test |
+ |
|
6. |
Cardiac Glycosides |
|
Keller Killiani test |
+ |
|
Sodium nitroprusside test |
- |
|
7. |
Glycosides |
|
Ferric Chloride test |
- |
|
Modified Borntrager’s test |
- |
|
8. |
Terpenoids |
|
Terpenes test |
- |
|
Iridoids(Monoterpenes) |
- |
|
Diterpenes test |
- |
|
*LibermannBurchard’s(Triterpenes) |
+ |
|
Salkowski’s test(Triterpenes) |
+ |
|
9. |
Steroids/Sterols |
|
Fluorescence test |
- |
|
*LibermannBurchard’s |
+(brownring) |
|
10. |
Alkaloids |
|
Mayer’s test |
- |
|
Wagner’s test |
- |
|
Dragendroff’s test |
- |
|
Hager’s test |
- |
|
11. |
Carbohydrates |
|
Molisch’s test |
- |
|
Benedict’s test |
- |
|
Fehling’s test |
- |
|
Iodine test |
+(Glycogen) |
|
12. |
Proteins and Aminoacids |
|
Xanthoproteic test |
- |
|
Ninhydrin test |
+ |
|
13. |
Resins |
|
Precipitation test |
- |
|
Turbidity test |
- |
|
14. |
Coumarins |
|
Fluorescence test |
- |
|
Alcoholic NaOH test |
- |
|
15. |
Volatile oils |
|
Colour test |
+ |
|
16. |
Phlobatannins |
|
Precipitation test |
- |
|
17. |
Anthraquinones |
|
Colour test |
- |
|
18. |
Peroxides |
|
Iodide test |
- |
+/-= Uncertain; += Presence, -=Absence; * Liebermann Burchard’s test: Formation of brown ring at the junction (Sterols), Upper layer turns green colour (Triterpenoids), Upper layer turns red or pink colour (Terpenoids)

Fig. 6: Graphical and pictorial representation of saponins hemolytic activity
Saponins from MSEwere extracted using thee different protocols with different solvents like hydrochloric acid [19], 32% hydrochloric acid [20] and benzene [21]. Out of the thee protocols extraction of saponins using benzene had given a better yield (fig. 7). These extracts were analyzed by performing TLC (7x3 cm). Separation of saponins was better with mobile phase-Pyridine: Butanol: water (3:2:1) (fig. 8).
Acidified extract of saponin (supernatent) was found with QSI activity when TLC plate was overlayed with bioindicator organism (fig. 9).
Fig. 7: QSI activity of saponin extracts controls for the saponins extract-a: Methanol, b: Water, c: 1 ml of 70% ethanol+0.1 ml of Conc. HCl, d: Benzene. A: Saponins extracted in methanol, B: saponins extracted in Water, C: Acidified extract of saponins (supernatent), D: Acidified extract of saponins (Precipitate in water), E: Benzene extract of Moringa seed

Fig. 8: TLC of saponins mobile phase: Pyridine: Butanol: water (3:2:1), a: Saponins extracted in Methanol, b: Saponins extracted in Water, c: Acidified extract of saponins (supernatant), d: Acidified extract of saponins (Precipitate in water), e: Benzene extract of Moringa seed

Fig. 9: QSI activity of saponins
Fig. 10: QSI activity of terpenes extracts C-Control T-terpenes extract
As cardiac glycosides, phytosterols, triterpenes extraction protocols overlap with one another, a common extraction procedure was followed and QSI activity of this extract was tested and depicted in fig. 10. The extracted fractions were later used to detect individual components of triterpenes, cardiac glycosides, phytosterols by performing specific TLC conditions as per the literature.
Cardiac glycosides were separated by the mobile phase-Ethylacetate: Pyridine: water (5:1:4) and Rf value of the resolved spot was 3.8 cm (fig. 11). Though these phytochemicals were resolved into individual spots on TLC sheets, only cardiac glycoside gave a positive reaction on TLC plates when overlayed with the bioindicator organism (fig. 12).
Extraction and TLC analysis of phytochemicals revealed that saponins had prominent QSI activity than cardiac glycosides, terpenes. After identifying the bioactive component, the next step was to understand the quorum quenching mechanism involved. Quorum quenching molecules are the compounds which are capable of interfering bacterial signaling processes. As microbial QS systems rely on QS signals and the cognate receptor proteins for gene regulation, any molecule that prevents accumulation of or recognition between QS signals and receptor proteins block bacterial QS-dependent virulence gene expression. The present study was made to understand the effect of MSE extract on signal molecule AHL. In order to understand the effect of phytochemicals on the signal molecule, pure AHL (C6-HSL, Sigma-Aldrich), was treated with MSE and the samples were subjected LCMS [23].

Fig. 11: TLC of cardiac glycosides. Mobile phase: ethyl acetate: pyridine: water (5:1:4)
The LCMS spectral data of AHL samples treated with MSE reveals that there is no fragmentation of AHL molecule (fig. 13). Generally a peak at m/z 102 indicates the characteristic Homoserine lactone ring alone and the fragmented acyl side chain will be indicated by small peaks [25]. So the QSI activity exhibited by MSE is not by signal inactivation or degradation as there was no presence of m/z 102 peak, so it could be by blocking the receptor from acceptor or inactivating the signal from AHL synthesis. Further research work had to be carried out to confirm the mechanism of action of phytochemicals.

Fig. 12: QSI activity of cardiac glycosides
Most of the QS inhibitors of natural origin were isolated and characterized from plant sources. Crude extracts of many plant parts were shown to possess QSI activity using C. violaceum as a model bacterium. Crude plant extracts are often found to be more effective than isolated components at an equivalent dose perhaps owing to positive interactions between components of whole plant extracts. This synergy may prevent the active component from degradation by enzymes or facilitate transport across cell barriers which result in the higher efficacy of the crude drug when compared with purified components. Hence, it is lately realized that crude extracts may possibly be the right strategy to treat multi-drug resistant pathogens as compared to the purified compound isolated from the same extract [26].

Fig. 13: LCMS spectral data of AHL samples treated with MSE
In the present study, the QSI activity of MSE was observed to be more when compared to individual compounds alone. The potential activity of MSE extract combined with its biofilm dispersal activity gives an opportunity to explore the possible usage of MSE in treating biofilms of drug-resistant bacterial infection. Plant food-associated with QS activity may be of therapeutic interest as the regular presence in the diet may positively affect the intestinal microbiota, preventing the concurrent invasion of pathogens. The continuing search for novel antimicrobial and antipathogenic agents focused on exploiting the fact that plants surviving in an environment with a high bacterial density may possess protective mechanisms for combating infections.
CONCLUSION
In the present study Moringa seed extract identified with potential QSI activity when tested against standard bioindicator organism. Extraction of individual phytochemicals from MSE like cardiac glycosides, saponins, terpenes, phytosterols was followed by their separation on TLC and tested for QSI activity with bioindicator organism. Cardiac glycosides and saponins alone showed mild violacein pigment inhibition when overlayed with bioindicator organism while the crude MSE showed a larger violacein pigment inhibition or QSI activity. Attempts were made to understand the mechanism involved in Quorum sensing inhibitory activity by LCMS analysis. This analysis indicated that signal molecule is not effected and it could be at the level either at signal production or at the receptor level which calls for further investigation in this regard. Present results give an opportunity to explore the possible usage of Moringa Seed extract in treating biofilm formation by a bacterial pathogen.
ACKNOWLEDGMENT
We sincerely thank Head, Department of Microbiology and the Management of Bhavan’s Vivekananda College for support and encouragement extended for Research. We acknowledge the help extended by Dr. Ganesh and Mr. Vidya Sagar, NCML, Hyderabad for LCMS analysis. We acknowledge UGC, New Delhi for the financial support to Dr. J. Sarada (UGC Major Research Project File no: 41-578/2012 sanctioned in 2012).
COMPETING INTERESTS
The authors hereby declare no competing financial conflict of interest.
REFERENCES
- Filomena Nazzaros, Florinda Fratianni, Raffaele Coppola. Quorum sensing and phytochemicals. Int J Mol Sci 2013;14:12607-19.
- Amy B Howell, Doris H D’Souza. The pomegranate: effects on bacteria and viruses that influence human health. J Evidence-Based Complementary Altern Med. 2013:11. doi: 10.1155/2013/606212. [Epub 20 May 2013]
- Xian Ding, Bo Yin, Li Qian, Zhirui Zeng, Zeliang Yang, Huixian Li, et al. Screening for novel quorum-sensing inhibitors to interfere with the formation of Pseudomonas aeruginosa biofilm. J Med Microbiol 2011;60:1827–34.
- Reema Al-Hussaini, Adel M Mahasneh. Microbial growth and quorum sensing antagonist activities of herbal plants extracts. Molecules 2009;14:3425-35.
- Y Aparna, K Sailendra, J Sarada. Evaluation of phytochemicals in certain Indian spices for quorum sensing inactivation in a plant pathogenic bacteria. Bioscan 2010;5:571-2.
- Y Aparna, S Uma Kranthi, J Sarada. Syzygium aromaticum-A common food spice with potential Quorum quenching activity on Serratia sps YAJS. Int J Curr Microbiol Appl Sci 2014;3:93-102.
- Farooq Anwar, Sajid Latif, Muhammad Ashaf, Anwarul Hassan Gilani. Moringa oleifera:a food plant with multiple medicinal uses. Phytother Res 2007;21:17–25.
- Sarada J, Uma Kranthi S. Quorum sensing inhibitory activity of calotropis gigantea: a tropical indian medicinal plant. Int J Pharm Phytopharm Res 2014;6:299-307.
- Maryam Zahin, Sameena Hasan, Farrukh Aqil, Mohd Sajjad Ahmad Khan, Fohad Mabood Hussain, Iqbal Ahmad. Screening of certain medicinal plants from India for their Antiquorum sensing inhibition activity. Indian J Exp Biol 2010;48:1219-24.
- Reindert Nijland, Michael J Hall, J Grant Burgess. Dispersal of Biofilms by Secreted, Matrix Degrading, Bacterial dnase. Plos One 2010;5:e15668.
- HO Edeoga, DE Okwu, BO Mbaebie. Phytochemical constituents of some nigerian medicinal plants. Afr J Biotechnol 2005;4:685-8.
- Das Talukdar, M Dutta Choudhary, M Chakraborty, BK Dutta. Phytochemical screening and TLC profiling of plant extracts of Cyathea gigantea (Wall. Ex. Hook.) Haltt. and Cyathea brunoniana. Wall. Ex. Hook. (Cl. and Bak.). Assam University J Sci Technol 2010;5:70-4.
- Prashant Tiwari, Bimlesh Kumar, Mandeep Kaur, Gurpreet Kaur, Harleen Kaur. Phytochemical screening and extraction: a review. Int Pharm Sci 2011;1:98-106.
- Oommen P Saj, Vinny KV. Antimicrobial, Anthelmintic and phytochemical investigation on Naragamia alata W and A. Int J Periodontics Restorative Dentistry 2011;3:37-48.
- Saxena Mamta, Saxena Jyoti. Phytochemical screening of Acorus calamus and Lantana camara. Int Res J Pharm 2012;3:324-26.
- Sunil H Ganatra, Shweta P Durge, Patil SU. Preliminary phytochemicals investigation and TLC analysis of ficus racemosa leave. J Chem Pharm Res 2012;4:2380-4.
- Showkat Ahmad Wani, KW Shah, Mir Ashfaq Ahmad. Preliminary phytochemical investigation and thin layer chromatography of Rheum emodi. Int Res J Pharm 2012;3:176-7.
- Laurence Voutquenne, Catherine Lavaud, Georges Massiot, Louisette Le Men-Olivier. Structure-activity relationships of hemolytic saponins. Pharm Biol 2002;40:1-10.
- George V. Odell and chuen-chin HSU. Isolation and purification of the saponin of glottidium vesicarium. In: George A Moore. editors. Proceedings of the Oklahoma Academy of Science, Oklahoma State University; 1966. p. 5-9.
- Youngmok Kim, Daniel J Wampler. Determination of saponin and various chemical compounds In Camellia Sinensis and Genus Ilex. Hamilton: Sensus; 2009.
- Veena Sharma, Ritu paliwal. Isolation and characterization of saponins from Moringa oleifera (moringaeceae) pods. Int J Pharm Pharm Sci 2013;5:179-83.
- JB Harborne. Phytochemical methods: A guide to modern techniques of plant analysis. Third edition. India: Haryana, Springer; 2011.
- Mair EA Churchill, Hiruy M Sibhatu, Charis L Uhlson. Defining the structure and function of Acyl-Homoserine Lactone autoinducers. In: Kendra P Ramburgh. editor. Quorum Sensing: Methods and Protocols, Methods in Molecular Biology, New York: Springer; 2011. p. 159-71.
- Sara M Soto. Importance of biofilms in urinary tract infections: new therapeutic approaches. Adv Biol 2014. doi.org/10.1155/2014/543974. [Article in Press]
- Dilara I Sharif, John Gallon, Chis J Smith, Ed Dudley. Quorum sensing in Cyanobacteria: N-octanoyl-homoserine lactone release and response, by the epilithic colonial Cyanobacterium gloeothece PCC6909. ISME J 2008;2:1171-82.
- Runu Ghosh, Bipransh Kumar Tiwary, Anoop Kumar, Ranadhir Chakraborty. Guava leaf extract inhibits quorum-sensing and Chromobacterium violaceum induced lysis of human hepatoma cells: whole transcriptome analysis reveals differential gene expression. Plos One 2014;9:e107703.